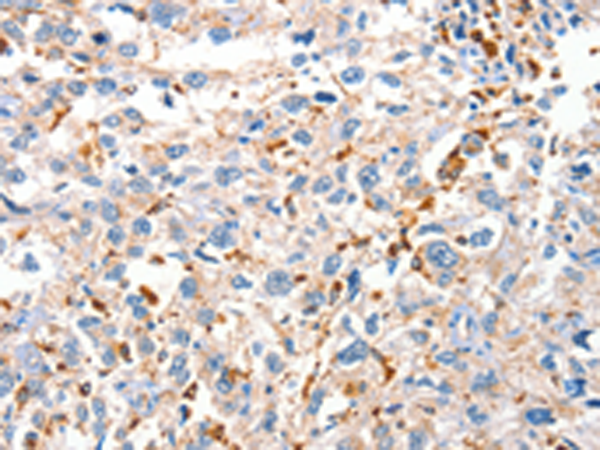
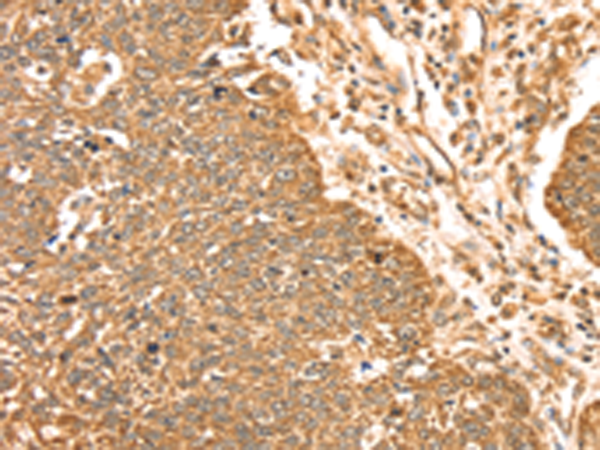

-
分类: 科研抗体货号: P07269别名: EF1G, GIG35应用: WB,IHC反应种属: Human, Mouse, Rat
-
分类: 科研抗体货号: P07281别名: MKP6; MKP-L应用: IHC反应种属: Human, Mouse
-
分类: 科研抗体货号: P07261别名: P62DOK应用: WB反应种属: Human, Mouse, Rat
-
分类: 科研抗体货号: P07280别名: BEDP; MDSP; TMDP; SKRP4; DUSP13A; DUSP13B应用: IHC反应种属: Human, Mouse
-
分类: 科研抗体货号: P07268别名: NG3; C6orf8应用: IHC反应种属: Human, Mouse, Rat
-
分类: 科研抗体货号: P07260别名: DOKL应用: WB,IHC反应种属: Human
-
分类: 科研抗体货号: P07279别名: VHX; JKAP; JSP1; MKPX; JSP-1; MKP-x; LMWDSP2; LMW-DSP2应用: IHC反应种属: Human, Mouse
-
分类: 科研抗体货号: P07298别名: SCDO5应用: IHC反应种属: Human, Mouse, Rat
-
分类: 科研抗体货号: P07258别名: C20orf180应用: IHC反应种属: Human, Mouse
-
分类: 科研抗体货号: P07278别名: BMK1; ERK4; ERK5; PRKM7应用: WB,IHC反应种属: Human, Mouse, Rat

鄂公网安备42018502007531号
鄂公网安备42018502007531号

